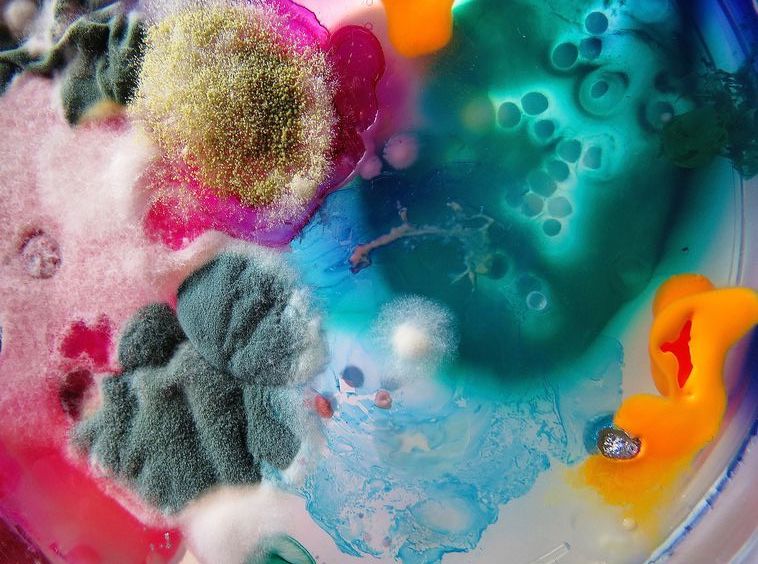

Unleashing the Power of Methylene Blue: From Medicine to Brain Enhancement
What is Methylene Blue?
Initially developed as a textile dye for blue jeans in 1876, it didn't take long for the potential of methylene blue to be discovered by the medical world. The first application was in treating malaria, and it was also used effectively in the fight against fungi, viruses, and bacteria, until prescription antimicrobials became available in the 1950s. Today, there has been increased interest in methylene blue due to studies suggesting that it may improve memory, be neuroprotective, cancer-combatting *AND* act as an anti-aging support due to its ability to be reduced into leucomethylene blue, a powerful antioxidant, by the body. Its small molecular size enables efficient delivery into tissues (which means it can get to work quickly!). Increasing amounts of research are showing how many health issues, concerns and conditions it can help with. Let’s get into them.
Methylene Blue and Skin Aging
First up, aging. Aging is driven by a reduction in elasticity, thinning of the skin, flattening of the dermal-epidermal junction, and a decrease in the amount of extracellular matrix (ECM). The aging process is also associated with an increase in reactive oxygen species (ROS) and increased oxidative damage, decreased collagen synthesis, and increased collagen breakdown, leading to accelerated aging. However, antioxidants are powerful in the game of anti-aging, and antioxidants like methylene blue can protect the skin and slow down the aging process. Research into methylene blue has shown that it can increase lifespan and cell proliferation in normal fibroblasts while reducing markers of aging. Aging is also marked by a decrease in mitochondrial mass, respiration capacity, and efficiency, and methylene blue can help with dysfunctional mitochondria. Its antioxidative properties are particularly effective in improving mitochondrial function and breaking the ROS-mitochondrial damage cycle. These findings also support the suggestion that methylene blue could be a promising anti-aging drug because its antioxidant nature can protect the skin and slow down the aging process.
Methylene blue has been shown to have other positive effects on skin health that can help prolong the aging process. We’re all after hydrated, thick skin and in a 3D skin tissue model, methylene blue treatment delivered just this. It also absorbs UV rays and mitigates DNA damage, which, in turn, can reduce oxidative stress and slow aging.
Methylene Blue, Brain Aging, Neurodegeneration and Brain Health
Alongside aging skin, methylene blue also has the potential to reduce brain aging by improving mitochondrial function. Again, this ties back to powering our mitochondria because mitochondrial dysfunction has been linked to neuronal loss and many brain diseases such as Alzheimer’s disease, Parkinson’s disease, and other brain injuries. Methylene blue has shown potential in reducing the progression of these diseases. The compound has been found to inhibit the aggregation of specific proteins, which are the hallmark features of Alzheimer's. Additionally, it has been shown to protect dopaminergic neurons in Parkinson's disease models and improve cognitive function in traumatic brain injury models.
Lab tests also suggest that methylene blue could be a potential treatment for optic neuropathy (degeneration of the retina) and other neurodegenerative conditions associated with mitochondrial dysfunction. Methylene blue has also shown promise as a memory enhancer by improving mitochondrial health and reducing oxidative stress, which can help maintain neuronal health and function in aging brains, giving it has the potential to not only slow brain aging and prevent or manage neurological conditions but also enhance brain activity and memory.
Methylene Blue and Cognitive Performance
Research also shows that methylene blue has a positive effect on cognitive performance in both animal and human studies by improving mitochondrial function, increasing cerebral blood flow, and enhancing neuroplasticity. Animal studies show it improves memory and cognitive flexibility, reduces age-related cognitive decline, and increases the number of dendritic spines in the brain. Human studies also show significant improvement in memory recall and cognitive function in healthy adults and those with mild cognitive impairment.
Methylene Blue and Cancer
Methylene blue has also shown potential as a cancer treatment in various studies and has been used in photodynamic therapy among different types of cancers, including lung cancer, breast cancer, and prostate cancer. One of its mechanisms of action is its ability to induce apoptosis (cell death) in cancer cells, without touching healthy cells. Methylene blue has also been found to inhibit tumor growth and metastasis in animal models of breast cancer and melanoma, as well as enhancing the effectiveness of chemotherapy drugs, such as cisplatin and doxorubicin, in killing cancer cells. Furthermore, it has also been found to have an anti-angiogenic effect, meaning that it can inhibit the formation of new blood vessels that supply nutrients to tumors, which is necessary for their growth and metastasis. Finally, ifosfamide-induced encephalopathy refers to a rare but serious neurological side effect of ifosfamide, a chemotherapy drug used to treat various types of cancer. Methylene blue is thought to be able to help in the treatment of this,
Methylene Blue and Phobias
Methylene blue may also have the amazing power to help manage life-altering and impacting phobias. In one study, adult participants with claustrophobia were given either a double-blind administration of methylene blue or a placebo, after six 5-minute trials in an enclosed chamber. The study found that it improved memory but maybe more importantly, helped with the reduction of fear when given after a successful exposure session.
Methylene Blue and Mood Enhancement
There is also some evidence to suggest that methylene blue may have potential as a treatment for depression. Research has shown that it can increase levels of serotonin and norepinephrine in the brain, which are neurotransmitters that play a role in regulating mood.
Methylene Blue as an Anti Infective
Methylene blue has also been studied for its potential antiviral properties, particularly against RNA viruses such as Zika virus and Dengue virus. One study found that it was able to inhibit the replication of Dengue virus in vitro, and another study found that it was able to inhibit Zika virus replication in both in vitro and in vivo experiments. Research has also suggested it may help in the fight against COVID and that low dose methylene blue, combined with certain spectrums of light (UV, primarily) help fight viruses.
Safety Notes
As with anything, it is important to dose with very good quality methylene blue and to talk to your doctor before self-dosing. Even pharmaceutical grade methylene blue may contain impurities such as arsenic, aluminum, cadmium, mercury, and lead, so getting the dosing right is critical. Studies have also shown that the effect of methylene blue can be dangerous when combined with rivastigmine, which may result in unexpected interactions. It is critically important to consult your doctor before using methylene blue and to not be sourcing from a chemical supplier.
Conclusion
People are taking methylene blue for various reasons, including its potential to improve cognitive function and memory, treat depression, and slow down the aging process. As mentioned above, it is also being studied for its potential to treat conditions such as Alzheimer's disease, Parkinson's disease, and certain types of cancer. However, it is important to note that, no matter how powerful it sounds, the use of methylene blue should always be discussed with a healthcare professional.
***THESE STATEMENTS HAVE NOT BEEN APPROVED OR REGULATED BY THE FDA. WE ARE NOT DOCTORS, THEREFORE ALWAYS CONSULT WITH YOUR DOCTOR FIRST***





